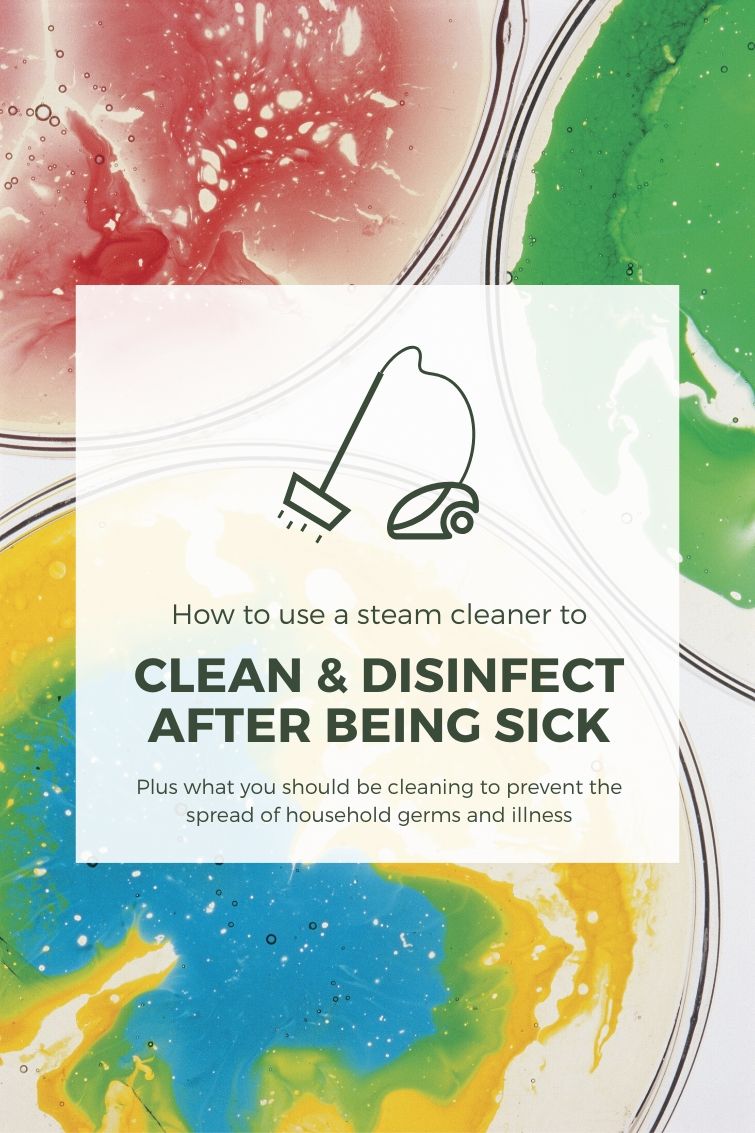
graphic showing a steam cleaner with a text overlay "Clean and Disinfect After Being Sick"

How to use a steam cleaner to clean, disinfect and kill germs after being sick.
My husband, who had been fighting a cold for a few days, was walking through our kitchen when the sneeze overtook him. It came so fast and forcefully he didn’t have time to grab a tissue or cover his nose with his hand.
Let’s just say I saw the germs spray everywhere. Ick!

After a nasty monthlong battle with the flu last year, I’m doing everything I can to prevent getting sick this year.
How To Clean Your House After Having the Flu (Or Another Contagious Illness)
In today’s post, I’m sharing tips on what you should clean and how to disinfect your home after someone has been sick with the flu, a cold, a stomach bug or another illness.
The secret to preventing the spread of illness is to clean and disinfect, according to the CDC.
Plus, I have a list of 25 household items and spaces you need to clean to prevent the spread of disease-causing germs and bacteria.
Did you know that you don’t have to use bleach or other harsh chemicals to clean and disinfect?
This is a sponsored post, and it contains affiliate links for your shopping convenience. Read my full disclosure policy here.
Cleaning with a Steamer
A steam cleaner is effective for cleaning, sanitizing and deodorizing. A steamer can be used on a variety of hard and soft surfaces around your home, including countertops, appliances, upholstery, carpet and sealed flooring.

After my husband and son both got sick with a nasty cold over the holidays, I was determined to not fall victim to the same bug.

So, I pulled out my trusty Wagner 915 On-Demand Steamer to disinfect those places where germs might be lurking. (I also did a lot of hand washing and practiced a lot of avoidance techniques while they were sick. No kissing or sharing food and drink while patients are contagious!)
Then I got to work deep steam-cleaning the house and killing disease-causing bacteria.

How to Use a Steamer to Clean & Disinfect
The Wagner steamer is super easy to use, and it will run for 45 minutes with a single 48-ounce fill.

Just use the provided funnel to fill the steamer, replace the cap, plug it in and allow the water to heat up. You’ll know it’s ready to start steaming and cleaning when only the green light is illuminated.

What temperature kills bacteria, germs and viruses?
Temperatures between 165 and 212 degrees Farhenheit are hot enough to kill, or neutralize, viruses and bacteria. That’s why you’ll often hear about boil-water advisories when a community’s water is deemed unsafe because of contamination.
Some types of bacteria require higher temperatures to kill than others. But a steam temperature of 212 F should quickly wipe out most bacteria, germs and dust mites.
The temperature of the water or the steam will determine how long you have to apply it to kill certain bacteria.
For example, steam cleaning a surface at 170 F for five minutes will kill the norovirus, which causes a nasty stomach bug. The same virus dies in just 1 minute when steam cleaned at 212 degrees F, according to the CDC.
The Wagner 915 produces steam in excess of 212 degrees, so disinfecting happens pretty quickly. The steam also has the added benefit of loosening dirt, grease and grime, so you don’t have to do a lot of scrubbing like you would with traditional cleaning methods or solutions.

There are two different brushes, along with the built-in steam jet nozzle, as well as a window squeegee, a large cleaning brush, two extension wands and a cleaning brush towel that turns the unit into a steam mop.
Be careful using a steamer on wood floors because the steam and moisture may damage wood. Be sure to read the manufacturers’ instructions and manual first, and you may also want to test the steamer in an inconspicuous area.

The Wagner steamer also comes with a steamer plate for removing wallpaper. But I’m still very much in love with my wallpaper, so I don’t think I’ll be using that accessory anytime soon.
The brush is useful for cleaning upholstery and rugs. But again, check the carpet or fabric instructions and test in an inconspicuous area first.

The squeegee is designed to be used on windows or shower doors, but it’s great on any large, hard surface.

I used the squeegee attachment to clean and disinfect our refrigerator, which is one of those forgotten hotspots for germs.
What should I clean after being sick?
When someone is sick, it’s a good idea to thoroughly clean your home to prevent the spread of illnesses and germs. In addition to thoroughly cleaning the infected person’s bedroom, the kitchen, bathrooms and the laundry room, don’t miss these potential hotspots where disease-causing bacteria can linger:
- countertops
- toilet levers
- shower faucets
- cabinet handles
- doorknobs

- refrigerator handles
- coffee pots
- microwave handles and keypads
- stove knobs

- sink faucets
- inside drawers
- laundry hampers and baskets
- bedposts
- nightstands

- toys
- video game controllers
- remote controls
- phones
- computer keyboards
- smart home keypads
- car keys
- bedding (sheets, pillowcases, comforters and blankets)
- rugs
- upholstery
For things that cannot be cleaned using a steamer, like electronics. light switches and remote controls, use disinfecting wipes with germ-killing capabilities. Wash linens at the highest temperature possible without damaging the fabric, and use bleach if possible.

More Wagner Products in Action
Every month, I’m sharing a new DIY project in partnership with Wagner using their paint sprayers, heat guns, rollers and other tools to inspire you to try them out for your own household and DIY projects.
Don’t miss these other projects of mine using Wagner products:
-
- DIY Outdoor Farmhouse Sink
- Painted Outdoor Furniture Makeover
- How to Paint Windsor Chairs Without Losing your Mind
- Removing Veneer with a Heat Gun
- Outdoor Bistro Chairs Makeover
- Tween Bed Makeover
- Painting Bamboo & Rattan Furniture with a Sprayer
- Nightstand with Faux Zinc Top Makeover
- Embossed Chalkboard Tags
- DIY Folding Camp Stool with Wood Burned Finish
- How to Paint a Ceiling Medallion
- Metallic Foiled Chinoiserie Christmas Ornaments
- Painted Christmas Tree Collar
- Alcohol Ink Coasters with a Heat Gun
Pin This! How to Clean & Disinfect with a Steam Cleaner
More Cleaning Tips & Tricks
For more cleaning tips and time-saving tricks, don’t miss these posts:
- 5 House Cleaning Tips when You’re Overwhelmed
- Time-Saving Cleaning Hacks with a Lint Roller
- 8 Tips to Take the Drudgery of Dirty Laundry
- Getting Rid of Odors in Old Furniture
- 1 Simple Laundry Trick to Save Loads & Time
- 13 Places Where Mold & Mildew Live in Your Home
- 8 Tips for Cleaner Dishes


Leave a Reply